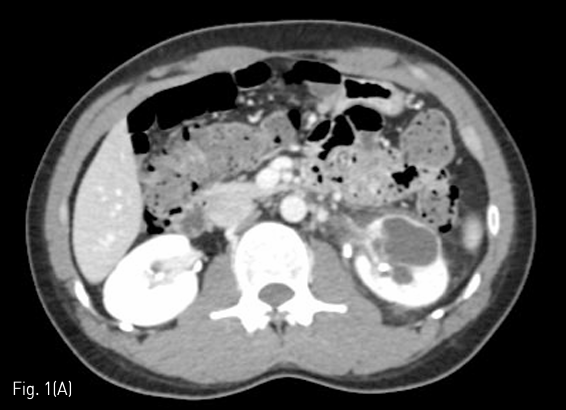

중심단어
Kidney, calyx, nephrostomy
한글 초록
26세 남자 환자가 왼쪽 신장의 낭성 병변에 대하여 fluid analysis 시행하여 진단된 isolated calyx의 stenotic infundibulum에 대하여 recanalization이 의뢰되었다. 저자들은 초음파 유도하에 isolated calyx 를 천자하여 stenotic infundibulum으로 유도 철선으로 통과시켜 nephrostomy 시행을 계획하였다. 그러나 renal pelvis와의 communication이 보이지 않아, isolated kidney에서 renal pelvis로 직접 천자하여 풍선확장술 후에 neoinfundibulotomy를 시행하고 8.5F nephrostomy catheter를 insertion 하였다. 이후 같은 경로를 통해 double J stent를 성공적으로 삽입하고 퇴원하였다.
영문 초록
A 26-year-old male was referred for recanalization of an isolated calyx on his left kidney. Isolated calyx was suspected by medical history was confirmed by aspirated fluid analysis. The authors planned nephrostomy catheter insertion through the stenotic infundibulum via percutaneous antegrade approach. However, the infundibulum was completely occluded. We attempted to create the neoinfundibulum with a sharp recanalization technique, which includes the puncture of the renal pelvis from the isolated calyx. A nephrstomy catheter was successfully placed through the neoinfundibulum. Three days after nephrostomy placement, a double J stent was placed via the same route and the patient was discharged without any complications. We want to report this case with review of literatures.
Introduction
Isolated calyx는 단일 또는 다수의 calyces가 renal pelvis와의 연결성이 없어져 생기는 질환으로 infundibulum의 obstruction이나 stenosis에 의해 발생한다. 이를 단순 신장 낭종으로 오진하여 percutaneous sclerotherapy를 시행할 경우 적절한 치료가 되지 않을 수 있으며 toxic sclerosing agent로 인한 요관 신우 접합부 협착과 같은 심각한 합병증이 발생gkf 수 있다. 본 증례에서는 isolated calyx를 소개하고 percutaneous antegrade approch를 통한 neoinfundibulotomy를 시행하여 치료하였기에 보고하고자 한다.
Case report
증례
26세/남자
임상소견
반복적인 신우신염의 병력이 있는 26세 남자 환자가 왼쪽 옆구리 통증 및 배뇨장애를 주소로 내원하였다. 내원하여 시행한 전산화 단층촬영에서 3.5cm 크기의 낭성 병변이 left kidney lower pole에 있었다. 낭성 병변에 drainage catheter를 insertion 하였다. Catheter를 통해 약 200ml/day 만큼의 fluid가 drainage 되었으며 이에 대하여 fluid analysis를 시행하였고, creatinine이 102 mg/dL)로 측정되었다.
진단명
Isolated renal calyx
영상소견
조영증강 전산화 단층촬영에서 왼쪽 신장의 아래쪽에 약 3.5cm 크기의 낭성 병변이 왼쪽 신장에 있었다. 내부에 조영증강의 소견이나 격벽은 없었으며 CT number는 0-15로 측정되었다. (Fig. 1A)
시술방법 및 재료
환자는 왼쪽 신장의 isolated calyx에는 8.5Fr. drainage catheter가 insertion 되어 있고 left renal pelvis에는 double J stent가 insertion 되어 있는 상태로 prone position을 취하였다. 기존의 drainage catheter에 0.035inch 유도 철사(Terumo, Tokyo, Japan)를 insertion 하고 catheter는 제거한 후 8Fr. Sheath(Boson, Shrewsbury, USA)를 삽입하였다. 조영제(Visipaque, GE healthcare, Chicago, USA)를 주사하여 tubogram을 시행하였고 isolated calyx 와 콩팥깔때기와의 연결성은 없었다. (Fig.1B) 초음파 유도 하에 21G 천자바늘(Cook, Bloomington, USA)로 isolated calyx를 천자하고 X선 투시하에 천자바늘을 콩팥깔때기에 insertion 되어 있는 double J catheter를 향해 진입시켰다. (Fig. 2A, B) 천자바늘의 속심을 제거한 후 X선 투시하에 조영제를 주사하여 isolated calyx를 지나 콩팥깔때기가 천자된 것을 확인하고 0.018inch 유도 철사(A & A, Gyeonggi, Korea)를 넣었다. (Fig. 2C) 이후 천자바늘을 제거하고 단일 막대 접근 장치(yellow sheath; A & A, Gyeonggi, Korea)를 이용하여 접근로를 확보했다. 유도 철사와 metal stiffening inner cannula를 제거하고 0.035inch 유도철사(Terumo, Tokyo, Japan)를 넣고 6mm x 4cm balloon(Boson, Shrewsbury, USA)을 이용하여 isolated calyx와 콩팥깔때기 간 neoinfundibulum 을 재건하였다. (Fig. 2D) 삽입되어 있는 유도 철사를 통해 isolated calyx, neoinfundibulum 그리고 콩팥깔때기를 차례로 통과하도록 10.2Fr. nephrostomy catheter(Cook, Bloomington, USA)를 위치시켰다. (Fig. 2E) 4일 후 기존의 10.2Fr PCN catheter insertion site를 통하여 10Fr sheath(Terumo, Tokyo, Japan)를 insertion 한 뒤 0.035inch 유도철사(Terumo, Tokyo, Japan)를 방광까지 진입시킨 뒤, 26cm 7Fr double J stent(Boson, Shrewsbury, USA)의 원위부는 방광에 위치시키고 근위부는 isolated calyx에 위치시켰다.(Fig. 3) 이후 isolated calyx로의 접근로에는 10.2Fr. nephrostomy catheter(Cook, Bloomington, USA)를 삽입하고 시술을 종료했다.
추적관찰
시술 후 nephrostomy catheter를 잠근 상태로 원활히 isolated calyx에서 생성된 오줌이 double J catheter를 통하여 방광으로 배출되는 것을 확인하였다. 시술 3주 뒤 추적 전산화 단층촬영에서 isolated calyx의 크기는 기존 3.5cm에서 1cm으로 작아졌다.
Fig 1A
(A) Nephrographic phase of contrast enhanced CT showed a 3.5cm sized cystic lesion in left kidney lower pole.
Fig 1B
(B) Tubogram did not show a connection between the isolated calyx and the renal pelvis.
Fig 2A
(A-B) Chiba needle was advanced under fluoroscopic guidance until entrance into the renal pelvis.
Fig 2B
(A-B) Chiba needle was advanced under fluoroscopic guidance until entrance into the renal pelvis.
Fig 2C
(C) Guide wire was passed through neoinfundibulotomy to renal pelvis.
Fig 2D
(D) Balloon dilatation was performed.
Fig 2E
(E) Nephrostomy catheter was inserted left renal pelvis through neoinfundibulum.
Fig 3
Ureteral stent was inserted left ureter through isolated calyx and neoinfundibulotomy.
고찰
Isolated calyx는 단일 또는 다수의 calyces가 renal pelvis와의 연결성이 없어져 생기는 질환이다. 원인으로는 신우신염, 요로결석, 악성종양, 내시경적 콩팥수술로 인한 외상, 그리고 collecting system closure after partial nephrectomy 등이 있다. 수신증이 있으며 antegrade or retrograde pyelography에서 dilated calyx가 조영되지 않거나 stenotic infuntibulum을 확인함으로써 진단된다. 환자는 주로 옆구리 또는 복부 통증, 혈뇨 그리고 하부 요로 증상이 있다. 본 증례에서는 제한된 공간에 오줌이 축적됨으로서 폐쇄 요로 병증의 증상인 옆구리 통증과 배뇨장애가 발생한 것으로 생각된다.
Isolated calyx의 치료 목표는 stenotic or obstructed infundibulum을 재개통해 줌으로써 오줌이 방광으로 적절하게 배액되도록 하는 것이다. 하지만 현재 standard practice guideline이나 treatment algorithm은 없다. 요도를 통한 retrograde method로 catheter나 stent를 위치시키는 방법이 있으며 내 시경상 dimple이나 scar가 있는 경우 Ho:YAG laser를 이용하여 infundibuloplasty를 시행할 수 있다. 콩팥 뒤쪽에 생긴 located calyx의 경우 percutaneous antegrade approach가 시도될 수 있다. 본 증례의 경우 percutaneous antegrade approach를 통한 stent insertion을 시도하였으나 infundibulum이 완전히 막혀 있어 guidewire가 통과되지 않았다. 따라서 isolated calyx 통하여 renal pelvis를 puncture 하여 neoinfundibulotomy를 시행하고 balloonplasty를 시행하였다. 이후 early scar formation을 예방하기 위하여 ureteral stent를 삽입하였고 향후 isolated calyx에서 만들어진 오줌의 neoinfundibulum을 통한 콩팥깔때기로의 흐름이 원활해질 것을 기대할 수 있다. 따라서 요로폐쇄와 연관된 임상증상의 호전과 영상검사를 통해 hydrocalyx가 없어지는지 추적 관찰하는 것이 필요하겠다.
참고문헌
1. Kwak J, Lee SH, Chung HH, Je BK, Yeom SK, Sung DJ. Isolated calyx mistaken for a cyst: Inappropriately performed catheter-directed sclerotherapy and safe removal of the catheter after selective embolization. Cardiovasc Intervent Radiol 2015;38:242-246
2. Mues AC, Landman J, Gupta M. Endoscopic management of completely excluded calices: a single institution experience. J Endourol 2010;24:1241-1245
3. Bruner B, Ashley R, Leibovich B, Blute M, LeRoy A. Case report: percutaneous catheter management of persistent urine leak due to iatrogenic infundibular stenosis after partial nephrectomy. J Endourol 2009;23:37-41
4. Skolarikos A, Laguna MP, de la Rosette JJ. Conservative and radiological management of simple renal cysts: a comprehensive review. BJU Int 2012;110:170-178
5. Waingankar N, Hayek S, Smith AD, Okeke Z. Calyceal diverticula: a comprehensive review. Rev Urol 2014;16:29-43
Citations
Citations to this article as recorded by